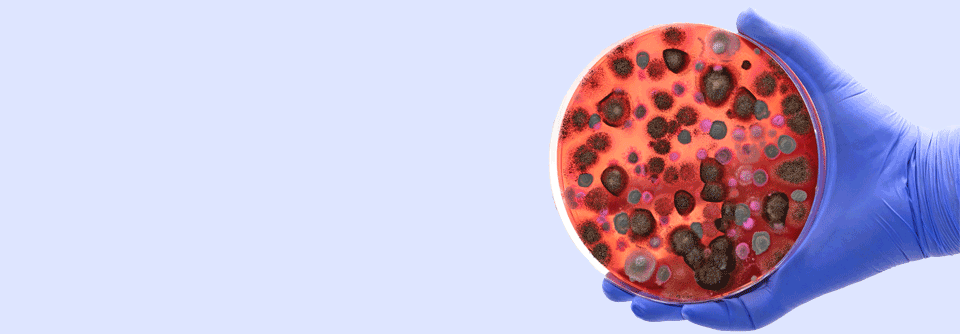

Immunsystem Das richtige Maß an Hygiene
 Mikroorganismen, mit denen man früh im Leben in Kontakt kommt, bilden die Mikrobiota und tragen zur Modulation des Immunsystems bei.
© iStock/LumiNola
Mikroorganismen, mit denen man früh im Leben in Kontakt kommt, bilden die Mikrobiota und tragen zur Modulation des Immunsystems bei.
© iStock/LumiNola
Mikroorganismen, mit denen man früh im Leben in Kontakt kommt, bilden die Mikrobiota und tragen zur Modulation des Immunsystems bei. Läuft dabei etwas schief, wird die Entwicklung chronisch-entzündlicher Erkrankungen wie z.B. Allergien begünstigt. Für derartige Störungen soll u.a. die Hygiene im Haushalt verantwortlich sein, die aber andererseits als lebensrettende Strategie gilt, schreiben Dr. Graham Rook vom Centre for Clinical Microbiology am University College London und Dr. Sally Bloomfield von der London School of Hygiene and Tropical Medicine.
Kinder so oft es geht in die Natur schicken
Die erste Frage, die sich stellt: Welche Mikroorganismen brauchen wir für eine gesunde Abwehr? Generell fangen wir uns zu Hause sowohl Keime von Mitbewohnern als auch aus den Gebäuden ein. Deren Substanz hat sich im Lauf der Jahre aber stark verändert. In alten Bauwerken aus natürlichen Baustoffen wie Holz, Stroh oder Stein unterschied sich das mikrobielle Spektrum nicht stark von dem in der Natur und enthielt damit viele Mikroorganismen, die für den Menschen von Vorteil sind. Moderne Häuser aus synthetischen Materialien sind dagegen ganz anders besiedelt. Lässt man sie dann noch verwahrlosen, können die vorhandenen Bakterien und Pilze toxische Metabolite bilden und ein Sick-Building-Syndrom auslösen. Eine solch ungesunde und unnatürliche Mikrobiota bietet Kindern keineswegs ideale Voraussetzungen. Kein Wunder also, dass man sie so oft es geht in die Natur schicken sollte.
Initial bietet den Kleinen vor allem der Mikroben-Transfer von der Mutter Schutz. Beeinträchtigt wird er durch Kaiserschnittgeburt, fehlendes Stillen und mangelnde Intimität zwischen Mutter und Baby.
Besser impfen als erkranken
Bis etwa zum 5. Lebensjahr bekommen die Kinder dann weitere Mikroorganismen-Booster durch den Vater, andere Familienangehörige und Menschen im näheren Umfeld, z.B. in der Kita. Was ist nun aber mit pathogenen Mikroorganismen? Nach wie vor vertreten einige Experten die Ansicht, dass Infektionen das Immunsystem stark machen bzw. halten. Die Autoren sagen dazu, dass Infektionen zwar nicht vor den chronisch-entzündlichen Erkrankungen schützen, aber möglicherweise die unspezifische Resistenz gegen andere Infektionen fördern. Potenziell lebensgefährliche Erkrankungen wie die Masern aber sollten vermieden werden, was dank Vakzinierungen gelingt. Und nach Ansicht der Londoner Kollegen verschaffen Impfungen dem Immunsystem genauso einen unspezifischen Schutz wie natürliche Ansteckungen, was im Übrigen auch für Erwachsene gelte. Daher: besser vorbeugen als anstecken.
Widersprüchliche Daten gibt es zum Einfluss von gründlichen Hygienemaßnahmen auf spätere Atopien und Asthma. In manchen Studien fanden sich Assoziationen, in anderen nicht. Der Einfluss hängt wohl in den meisten Fällen weniger vom Putzen selbst als vom benutzten Putzmittel sowie der Formulierung ab (z.B. Sprays). Produkte mit Detergenzien und quartären Ammoniumverbindungen, wie sie Reinigungspersonal verwenden, werden epidemiologisch sicher in Zusammenhang mit Asthma gebracht. Sie sind zelltoxisch, erhöhen die epitheliale Permeabilität, und einige enthalten potente Allergene. Chemische Reinigungsmittel fördern zudem die Th2-Antwort und begünstigen so allergische Reaktionen.
Die Devise muss daher lauten: Infektionen verhindern, ohne die Exposition gegenüber essenziellen Mikroorganismen zu verhindern und ohne zu schaden. Das gelingt mit einem gezielten Konzept, das Experten über die letzten Jahrzehnte hinweg entwickelt haben. Dafür wurden neun Tätigkeiten definiert, die eine Schlüsselposition einnehmen und in denen Hygiene eine besondere Bedeutung hat, um Infektionen zu verhindern:
- mit Lebensmitteln umgehen
- mit den Fingern essen
- die Toilette benutzen
- Windeln wechseln
- Husten, Niesen, Nase putzen
- Oberflächen anfassen, die von vielen anderen Menschen ebenfalls berührt werden
- mit Kleidung, Bettwäsche und Handtüchern hantieren
- Haustiere versorgen
- mit Abfall umgehen
Diese Situationen verdienen noch mehr Aufmerksamkeit, wenn man infizierte Familienangehörige pflegt, sonst droht die Verbreitung der Infektion. Und beinahe bei allen genannten Tätigkeiten sind es vor allem die Hände, die der verschärften Sauberkeit bedürfen.
Keimfreiheit auf Flächen ist kaum erreichbar und unnötig
Böden und die meisten Oberflächen im Haushalt gelten generell im Hinblick auf Infektionen als risikoarm. Sie sind kaum mit pathogenen Keimen besiedelt, es sei denn, sie werden mit Fäkalien oder Erbrochenem kontaminiert oder es handelt sich um Bereiche, in denen krabbelnde Kinder mit Haustieren spielen. Außerdem lohnt das mühsame Putzen und Desinfizieren auf Oberflächen kaum: Studien zeigen, dass die Mikroben binnen weniger Stunden ihr Terrain zurückerobern.
Das „Hygienetheater“
- der Versuch, Böden und andere Oberflächen zu sterilisieren
- Tiefenreinigung und Vernebelung ganzer Räumlichkeiten
- einen „Tunnel“ einzurichten, in dem sich Besucher vor dem Eintritt desinfizieren lassen müssen, z.B. in Stadien
- Sprayen und Vernebeln von offenen Bereichen, z.B. Straßen oder U-Bahn- Stationen, wie es einige Länder praktizieren.
Quelle: Rook GAW, Bloomfield SF. J Allergy Clin Immunol 2021; 148: 33-39; DOI: 10.1016/j.jaci.2021.05.008